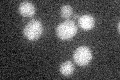
YBL069W
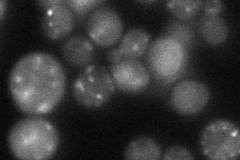
YBL069W

View description
Peripheral membrane protein that interacts with the plasma membrane ATPase Pma1p and has a role in its targeting to the plasma membrane, possibly by influencing its incorporation into lipid rafts
Localization:
Intensity:
Fold change:
Significance:
-
C’ GFP library in SD
below threshold14.97 -
N' NOP1pr-GFP in SD

punctate103.32 -
N' TEF2pr-mCherry in SD

cytosol,punctate185.668 -
N' NATIVEpr-GFP in SD
punctate32.1987 -
N' TEF2pr-VC and Cyto-VN in SD

cytosol54.7013 -
C’ GFP library in SD+DTT

cytosol14.550.97No -
C’ GFP library in SD+H2O2

cytosol14.650.97No -
C’ GFP library in Starvation Media

cytosol15.341.02No -
C’ GFP library on the background of Pup2-DaMP

below threshold -
C’ GFP library on the background of CCT mutant

below threshold14.99331.00115No
